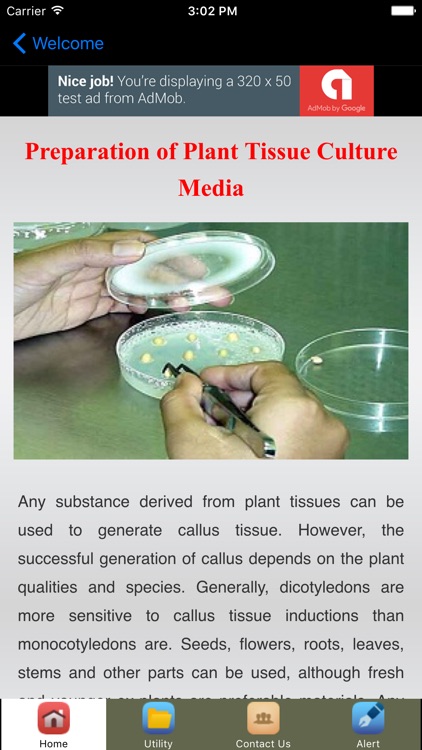
Tissue Culture Techniques screenshot-3

Tissue culture is a technique with which plant cells, tissues or organs are grown on artificial nutrient medium, either static or liquid, under aseptic and controlled conditions

Tissue Culture Techniques



What is it about?
Tissue culture is a technique with which plant cells, tissues or organs are grown on artificial nutrient medium, either static or liquid, under aseptic and controlled conditions. The key word behind the success of tissue culture is the totipotency.

App Screenshots

App Store Description
Tissue culture is a technique with which plant cells, tissues or organs are grown on artificial nutrient medium, either static or liquid, under aseptic and controlled conditions. The key word behind the success of tissue culture is the totipotency.
Callus culture works on some basic principles. These are aseptic preparation of plant material, selection of suitable growth medium (auxin : cytokinin ratio is important to consider), selection of suitable controlled physical growth conditions for incubation.
In this application includes nice articles and tips.
ans also we have include some utility to help you keep track of your progress.
Features:
1 Plant Tissue Culture Techniques
2 Preparation of Plant Tissue Culture Media
3 The Varied Advantages of Tissue Culture Plates and Dishes
4 Beneficial Features of Tissue Culture Dishes
5 Cell Culturing
6 Tissue Culture Applications To Improve Crops
and many more.
Try it now! Download Tissue Culture Techniques and you can Learn all this Tissue Culture Techniques for free!
AppAdvice does not own this application and only provides images and links contained in the iTunes Search API, to help our users find the best apps to download. If you are the developer of this app and would like your information removed, please send a request to takedown@appadvice.com and your information will be removed.